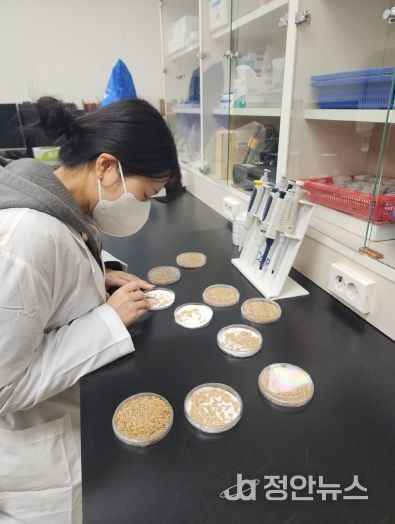

정안뉴스 안정주 기자 | 진안군이 2026년, 지역 농업인들의 원활한 영농 준비를 위해 벼 자가채종 종자에 대한 발아율 검사를 무료로 실시한다.
이번 무료 검사는 우량종자 확보가 벼농사의 가장 중요한 요소임을 감안해 처음으로 시행된다.
군은 정부 보급종 공급량 감소로 자가채종 종자를 다음 해에 사용하는 농가가 증가함에 따라, 발아 불량 종자가 나올 우려가 있어, 벼 종자 파종 전인 오는 4월까지 발아율 검사를 실시할 계획이다.
발아율 검사는 종자의 싹을 틔워 확인해 정상묘의 비율을 측정하는 과정으로, 정부 보급종의 경우 발아율 85% 이상일 때만 종자용으로 사용 가능하다.
검사를 희망하는 농업인은 볍씨 시료 500g(종이컵 3컵 분량)과 신청서를 작성하여, 진안군농업기술센터 식량자원팀에 제출하면 된다. 검사 결과는 4번을 반복 실험하여 도출한다. 검사 기간은 7~10일 정도가 소요되며, 신청량이 많을 경우 소요 기간은 늘어날 것으로 예상된다.
진안군농업기술센터 노금선 소장은 “자가채종 종자를 사용할 경우 반드시 발아력을 확인해 주시기 바란다”고 당부했다.






















